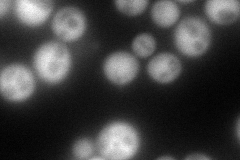
YNR057C
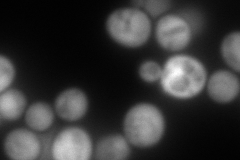
YNR057C
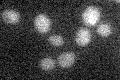
YNR057C

View description
Dethiobiotin synthetase, catalyzes the third step in the biotin biosynthesis pathway; BIO4 is in a cluster of 3 genes (BIO3, BIO4, and BIO5) that mediate biotin synthesis; expression appears to be repressed at low iron levels
Localization:
Intensity:
Fold change:
Significance:
-
C’ GFP library in SD

below threshold17.23 -
N' NOP1pr-GFP in SD
cytosol170.04 -
N' TEF2pr-mCherry in SD
cytosol294.14 -
N' NATIVEpr-GFP in SD

cytosol23.8844 -
N' TEF2pr-VC and Cyto-VN in SD

cytosol68.6285 -
C’ GFP library in SD+DTT

cytosol17.281No -
C’ GFP library in SD+H2O2

cytosol15.420.89No -
C’ GFP library in Starvation Media
cytosol17.090.99No -
C’ GFP library on the background of Pup2-DaMP

below threshold -
C’ GFP library on the background of CCT mutant

below threshold17.01310.98701No
